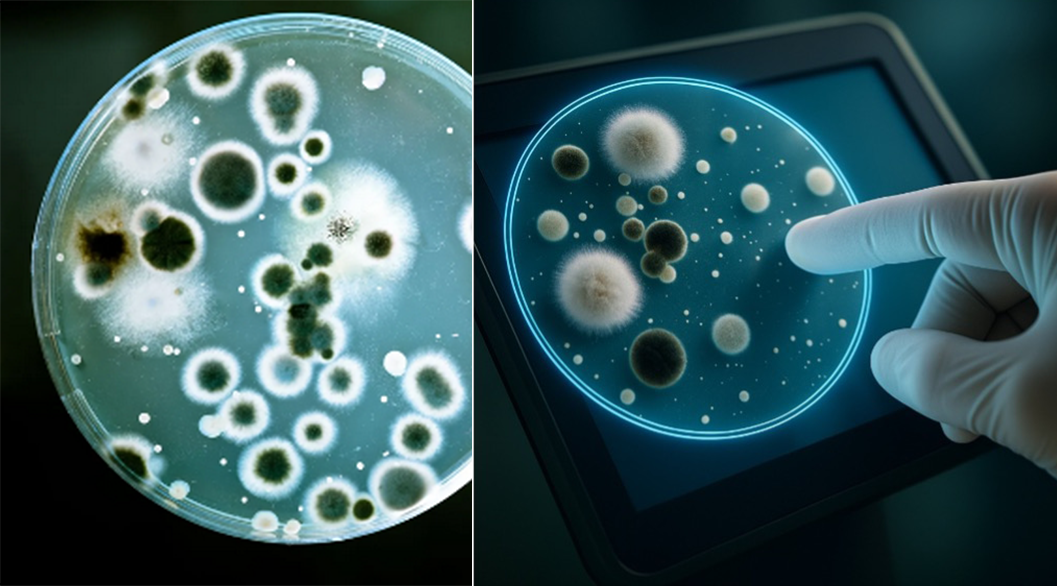

Mikrobiologiczne zagrożenia związane z ekranami dotykowymi w przestrzeni publicznej
Dotykanie powierzchni w przestrzeni publicznej jest nieodłącznym elementem codziennego życia. Zwykłe czynności jak zakupy (np. kasy samoobsługowe), podróże komunikacją miejską (ekrany biletomatów, uchwyty), interaktywne kioski, automaty, stacje ładowania EV czy korzystanie z bankomatu – wymagają interakcji z powierzchniami, które są dotykane przez setki, a nawet tysiące ludzi dziennie.
Źródło grafiki: gpt
Choć rzadko się nad tym zastanawiamy, wiele z tych miejsc stanowi realne ogniska zagrożenia mikrobiologicznego. Często ignorowany aspekt higieny – czystość wspólnych powierzchni – może w rzeczywistości jednym z głównych kanałów transmisji groźnych patogenów: bakterii, wirusów i grzybów odpowiedzialnych za groźne choroby. To, że ich nie widzimy, nie oznacza, że jesteśmy bezpieczni w interakcjach z urządzeniami wyposażonymi w ekrany dotykowe. Doskonały przykład stanowi pandemia covid-19, choć codzienne zagrożenie jest zdecydowanie bardziej ignorowane.
W artykule przyglądam się wybranym, aktualnym badaniom na temat mikrobiologicznych zagrożeń związanych z kontaktem z powierzchniami wspólnymi w przestrzeni publicznej. Podaję także rekomendacje, w tym technologiczne, które mogą istotnie ograniczyć ryzyko potencjalnych infekcji.
Wózki sklepowe i kasy samoobsługowe – powierzchnie dnia codziennego
Badanie przeprowadzone przez Uniwersytet Arizony wykazało, że aż 72% testowanych wózków sklepowych było skażonych bakteriami z grupy coli, a w 51% przypadków wykryto obecność Escherichia coli (E. coli), co sugeruje możliwe skażenie fekalne (Gerba & Maxwell, 2012). Podobne badania przeprowadzono na ekranach dotykowych w sklepach i szpitalach – wykryto Staphylococcus aureus, Clostridium difficile oraz enterokoki odporne na wankomycynę (Gerba et al., 2014).
Podobne wyniki uzyskano w badaniu przeprowadzonym w roku 2012 w Kanadzie, gdzie aż 61% wózków zawierało patogenne bakterie, w tym MRSA (Methicillin-Resistant Staphylococcus aureus). Było to potwierdzenie badania Mizumachiego z roku 2011, gdzie obecność 52 szczepów tej bakterii wykryto na uchwytach 760 koszyków zakupowych, wskazując na potrzebę ich regularnej dezynfekcji .
W brytyjskim badaniu przeprowadzonym w 2018 roku przez dziennik „Metro UK” we współpracy z naukowcami z London Metropolitan University potwierdzono brak skutecznego czyszczenia i dezynfekcji na samoobsługowych ekranach dotykowych w restauracji McDonald’s. Ponadto wykryto drobnoustroje na wszystkich ekranach dotykowych, w tym Enterococcus faecalis oraz Listeria monocytogenes oraz sformułowano wniosek, że ekrany dotykowe w miejscach publicznych, szczególnie w restauracjach szybkiej obsługi, mogą stanowić realne źródło transmisji patogenów. To jedynie potwierdza globalny charakter problemu.

Escherichia coli. Źródło: https://www.cdc.gov/ecoli/about/kinds-of-ecoli.html (dostęp 30.05.2025)
W zasadzie te łacińskie nazwy bakterii niewiele nam mówią, ale spójrzmy jakie choroby możemy im zawdzięczać dzięki kontaktowi z brudnymi powierzchniami:
- Escherichia coli (E. coli) to bakteria jelitowa, która może mieć zarówno szczepy niepatogenne, jak i wysoce chorobotwórcze. Wywołuje najczęściej choroby związane z zakażeniami przewodu pokarmowego (np. biegunki, krwotoczne zapalenie jelita grubego – szczep EHEC), zakażenia dróg moczowych czy sepsę i zapalenie opon mózgowo-rdzeniowych (u noworodków); źródło: https://www.cdc.gov/ecoli/about/kinds-of-ecoli.html (dostęp 30.05.2025)
- Staphylococcus aureus to gram-dodatni gronkowiec, często kolonizujący skórę i błony śluzowe, odpowiedzialny za m.in.: czyraki, ropnie, zapalenia mieszków włosowych, zakażenia ran, zapalenie płuc i zespół wstrząsu toksycznego (TSS);
- Methicillin-Resistant Staphylococcus aureus (MRSA) to odmiana Staphylococcus aureus odporna na antybiotyki (w tym metycylinę) dlatego wywołane choroby są trudniejsze w leczeniu. Często powoduje zakażenia szpitalne (HA-MRSA).
- Clostridium difficile to beztlenowa bakteria tworząca przetrwalniki (bardzo odporne formy bakterii). Prowadzi do ciężkiego zapalenia jelit, biegunek poantybiotykowych;
- Enterococcus faecalis / enterokoki to bakterie naturalnie występujące w jelicie grubym, ale mogą być oportunistyczne (wywołują choroby w warunkach osłabienia organizmu lub w przypadku dostania się w niewłaściwe miejsce). Groźne jest to, ze są odporne na wiele antybiotyków a mogą prowadzić do zakażenia dróg moczowych, zakażenia ran czy nawet sepsy;
- Listeria monocytogenes to gram-dodatnia bakteria pałeczkowata, przenoszona najczęściej przez żywność. Prowadzi do Listeriozy (groźnej szczególnie dla kobiet w ciąży, noworodków i osób z obniżoną odpornością) czy zapalenia opon mózgowo-rdzeniowych, a także sepsy;

Źródło https://naszesprawy.eu/wp-content/uploads/2020/10/HCV-wirus.jpeg (dostęp 30.05.2025)
Kontakt z zanieczyszczonymi powierzchniami może prowadzić do zakażenia wirusami zapalenia wątroby typu A i E – wirusami wysoce odpornymi na warunki środowiskowe. Czeskie badania potwierdzają, że są one przenoszone drogą fekalno-oralną i szczególnie niebezpieczne w przestrzeni publicznej. Dane z lat 2013–2017 pokazują wyraźny wzrost przypadków VHA i VHE w Czechach: np. VHA – z 348 przypadków w 2013 r. do 930 w 2016 r., a VHE z 218 do 344 .
Natomiast z danych epidemiologicznych wynika również, że zakażenia RSV (respiratory syncytial virus), przenoszący się przez powietrze i dotyk, był przyczyną 1865 hospitalizacji w 2023 roku, z czego 63% dotyczyło dzieci poniżej 1 roku życia. Niepokojące jest to, że wirus RSV może przetrwać na powierzchniach nawet kilka godzin. W USA rotawirusy i norowirusy powodują co roku miliony przypadków biegunek u dzieci i osób starszych, często poprzez kontakt z zanieczyszczonymi powierzchniami (CDC, 2022).
Przeglądając dostępne w sieci raporty, artykuły można przytoczyć wiele podobnych przykładów. Jednak analiza powierzchni w przestrzeni publicznej pokazuje wyraźnie, że zanieczyszczenie mikrobiologiczne ekranów dotykowych występuje niemal w 100%, bankomatów w 90%, a wózków sklepowych w ponad 70% (szacunki własne autora).
Transport publiczny
Analiza mikrobiologiczna przeprowadzona w Czechach w 2025 roku na powierzchniach w tramwajach i autobusach wykazała niemal w 95% obecność bakterii tlenowych mezofilnych, gronkowców koagulazo-dodatnich (Staphylococcus aureus), enterobakterii i grzybów. Potwierdza to wcześniejsze badania z Wielkiej Brytanii z 2009, które wykryły podobne zanieczyszczenie badanych powierzchni w autobusach, pociągach i stacjach metra, gdzie wykryto głownie Staphylococcus aureus. Ocena powierzchni w transporcie publicznym (autobusy, metro, tramwaje) wykonana w 2019 roku w Neapolu potwierdziła natomiast znaczące skażenie mikrobiologiczne, a 30% wykrytych szczepów bakterii wykazywało oporność wielolekową (MDR).

Źródło grafiki: gpt
Dodatkowo, badania przeprowadzone w Londynie przez mikrobiologów z London Metropolitan University ujawniły obecność 121 różnych szczepów bakterii i pleśni na powierzchniach transportu publicznego, w tym 9 szczepów opornych na antybiotyki. Najbardziej zanieczyszczoną linią metra okazała się linia Victoria, na której stwierdzono obecność 22 różnych szczepów bakterii, w tym Staphylococcus aureus, Escherichia coli i Klebsiella pneumoniae. W Stanach Zjednoczonych, badania przeprowadzone w Bostonie wykazały, że najczęściej występujące bakterie na powierzchniach metra pochodzą z ludzkiej skóry i jamy ustnej. Choć nie stwierdzono obecności patogennych organizmów ani genów oporności na antybiotyki, badacze podkreślają znaczenie monitorowania środowiska mikrobiologicznego w transporcie publicznym.
Co ciekawe, badania pokazują, że największe kolonie bakterii występują na podłogach i siedzeniach z tkaniny oraz uchwytach, głownie właśnie Staphylococcus aureus, w tym szczepy odporne na penicylinę czy ampicylinę. Nieco nadziei wnoszą badania z 2023 przeprowadzone w Toronto i Vancouver. Wykazano w nich, ze po roku użytkowania powierzchnie z miedzi wykazywały ponad w 42% redukcję liczby bakterii w porównaniu do standardowych powierzchni.
To tylko część dostępnych badań, ale podkreślają one globalny charakter problemu zanieczyszczenia mikrobiologicznego w transporcie publicznym. Konieczność wdrażania skutecznych środków higieny jest także zauważona przez instytucje unijne. Wprawdzie brak jest konkretnych regulacji prawnych dotyczących higieny powierzchni w transporcie publicznym, ale istnieją ogólne przepisy (rozporządzenie nr 852/2004 czy nr 2073/2005) , i inicjatywy mające na celu poprawę higieny w przestrzeniach publicznych (np. projekt SelfClean opisany dalej). Wiele krajów członkowskich opracowuje własne wytyczne i standardy w tym zakresie, często opierając się na zaleceniach ECDC (Europejskie Centrum ds. Zapobiegania i Kontroli Chorób) w kwestii monitorowania obecności patogenów na powierzchniach często dotykanych przez pasażerów. Należy jednak pamiętać o trendach, które przenikają do komunikacji publicznej – nie tylko uchwyty czy siedzenia stwarzają zagrożenie, ale także coraz powszechniejsze ekrany dotykowe w biletomatach czy systemach informacji pasażerskiej. Obecnie wiele z nich jest w wersji pasywnej (wyświetla informację), ale już za chwilę będziemy się mierzyć ze wszystkimi zagrożeniami związanymi z dotykaniem ekranów interaktywnych opisanymi powyżej.
Wyposażenie szpitalne
Badanie przeprowadzone w USA wykazało, że 25% sprzętu medycznego w oddziałach ratunkowych było skażonych klinicznie istotnymi mikroorganizmami, pomimo standardowej dezynfekcji ręcznej. Natomiast w polskich badaniach opublikowanych w 2025 roku stwierdzono obecność bakterii na często dotykanych powierzchniach w klinikach ambulatoryjnych. Najczęściej izolowano bakterie odporne na antybiotyki, takie jak Bacillus spp. Wyniki badania skłoniły do rewizji procedur czyszczenia w badanych placówkach.
Badanie przeprowadzone w 2016 roku w szpitalach i sklepach spożywczych w USA wykazało obecność patogenów oportunistycznych na ekranach dotykowych komputerów. W szpitalach izolowano m.in. Clostridium difficile i enterokoki oporne na wankomycynę (VRE). Natomiast na ekranach w sklepach spożywczych stwierdzono obecność gronkowca złocistego opornego na metycylinę (MRSA) oraz bakterii jelitowych, takich jak Escherichia coli. Natomiast badanie przeprowadzone w Japonii w 2021 roku podaje, że 58,3% smartfonów używanych przez personel medyczny było skażonych bakteriami. Przy czym zidentyfikowano obecność bakterii na każdej powierzchni. Tylna powierzchnia urządzeń była bardziej zanieczyszczona (46% przypadków) niż ekran dotykowy.

Źródło grafiki: gpt
Ekrany dotykowe, zarówno w szpitalach, jak i w miejscach publicznych, mogą stanowić rezerwuar patogenów, co tylko podkreśla potrzebę regularnej dezynfekcji tych powierzchni. W większości przypadków źródłem są ręce personelu lub zanieczyszczone urządzenia i powierzchnie. Badania potwierdzają, że ekrany dotykowe oraz sprzęt medyczny w szpitalach mogą być rezerwuarem patogenów, w tym szczepów opornych na antybiotyki. Regularna dezynfekcja tych powierzchni oraz przestrzeganie zasad higieny rąk przez personel medyczny są kluczowe w zapobieganiu zakażeniom związanym z opieką zdrowotną.
Higiena rąk – podstawowe narzędzie profilaktyki
Według WHO, mycie rąk to najskuteczniejszy sposób zapobiegania infekcjom. Niedostateczna higiena rąk pracowników ochrony zdrowia znacząco zwiększa ryzyko zakażeń szpitalnych. WHO rekomenduje strategię „5 momentów dla higieny rąk” jako podstawę przeciwdziałania transmisji patogenów (WHO, 2009).

Zdjęcie: Mariusz Duczek
Metaanaliza z 2020 roku opublikowana w „Lancet Infectious Diseases” wykazała, że programy promocji higieny rąk zmniejszają liczbę zakażeń szpitalnych o 40%.
Bardziej skutecznym rozwiązaniem jest stosowanie automatycznych urządzeń do dezynfekcji powierzchni (tzw. SUDS). Zazwyczaj wykorzystywanych do dezynfekcji sprzętu medycznego (stetoskopy, ciśnieniomierze, skanery), urządzeń elektronicznych (tablety, ekrany) czy biletomatów w transporcie publicznym. Zwykle wykorzystane jest to promieniowanie UV-C lub mgła nadtlenkowa, ale wymaga umieszczenia sprzętu w komorze dezynfekującej. Niemniej ma 100% skuteczność.
Technologia samoczyszcząca
W odpowiedzi na rosnące ryzyko transmisji patogenów z pomocą powierzchni dotykowych, warto rozważyć zastosowanie rozwiązań antybakteryjnych takich jak Lotus Foil. To samoczyszcząca folia, opracowana przez firmę FORTES Interactive, czeskiego producenta rozwiązań dotykowych, która zawiera silnie reaktywną substancję – tlen singletowy (właściwości biobójcze). Działa skutecznie (ponad 99,9% redukcji bakterii) przeciwko E. coli, Staphylococcus aureus (w tym MRSA), wirusom zapalenia wątroby A i E oraz SARS-CoV-2.

Folia działa samoczynnie i nieprzerwanie przez co najmniej 12 miesięcy. Przeszła testy zgodne z międzynarodowymi wymaganiami ISO 21702 (działanie przeciwwirusowe) oraz ISO 22196 (przeciwdziałanie rozwojowi bakterii). Minimalizuje ryzyko transmisji zakażeń przez powierzchnie dotykowe w przestrzeni publicznej, medycznej i komercyjnej. Najczęstsze zastosowanie to monitory dotykowe, panele wind, bankomaty, urządzenia medyczne, terminale POS itp.
Podsumowanie
Skoro badania jednoznacznie pokazują, że wiele powierzchni w przestrzeni publicznej – jak ekrany dotykowe, uchwyty w komunikacji, wózki sklepowe czy sprzęt medyczny – jest zanieczyszczonych mikroorganizmami (w tym patogenami opornymi na antybiotyki), to dlaczego nie chorujemy codziennie?
Zawdzięczamy to przede wszystkim sprawnie działającemu układowi odpornościowemu, który neutralizuje większość drobnoustrojów zanim zdążą wyrządzić szkodę. Pomagają nam również proste nawyki higieniczne jak zwykłe mycie rąk, które skutecznie przerywają łańcuch zakażenia. Warto też pamiętać, że nie każda bakteria jest chorobotwórcza, a wiele kontaktów z patogenami kończy się bezobjawowo. Co więcej, obecność mikroorganizmów wykrywana w badaniach nie zawsze oznacza realne zagrożenie, ponieważ często są to nieaktywne ślady DNA. Wreszcie, nawet częściowe czyszczenie powierzchni oraz nowoczesne rozwiązania, jak samoczyszczące folie, znacząco ograniczają ryzyko transmisji infekcji. Mimo że otaczają nas bakterie i wirusy to nie jesteśmy wobec nich bezbronni, ale jak pokazuje pandemia COVID-19 zaniedbanie tych zaleceń może szybko doprowadzić do eskalacji zagrożenia.
Mamy jedną parę oczu i dziesięć palców. Sama natura kieruje nas ku technologii dotykowej, a pokolenie Z czy Alfa tylko przyśpieszy ten trend ponieważ dotykanie jest intuicyjne, szybkie i naturalne. Jednocześnie jednak dotyk jest najczęstszym i najbardziej bagatelizowanym kanałem transmisji patogenów. Z przedstawionych danych epidemiologicznych oraz mikrobiologicznych wynika jednoznacznie, że powierzchnie w przestrzeni publicznej, choć pozornie nieszkodliwe, mogą być skażone bakteriami i wirusami zagrażającymi zdrowiu. W dobie rosnącej oporności na antybiotyki oraz wirusów o wysokim potencjale transmisji, takich jak RSV czy SARS-CoV-2, świadomość zagrożeń oraz promocja higieny stają się fundamentem zdrowia publicznego.

Folia Lotus w sklepie Billa, Czechy. Zdjęcie: Mariusz Duczek
W świetle globalnych doświadczeń inwestycja w prewencję, czy edukację już nie wystarczy. Nie wystarczy apel o mycie rąk – potrzebne są rozwiązania systemowe związane z czyszczeniem powierzchni i nowoczesne technologie. Zakończony w 2015 roku Projekt SelfClean, finansowany przez UE, zakończył się opracowaniem powłok kompozytowych, których skuteczność, potwierdzona badaniami, może zmniejszyć ryzyko infekcji w środowiskach szpitalnych o ponad 60%. Dziś dysponujemy bardziej skuteczną technologią, np. folia Lotus niszczy każdego dnia ponad 99,9% bakterii z powierzchni dotykowych i mogłaby być standardem dla ekranów dotykowych w sklepach, szpitalach, transporcie i wszędzie tam gdzie wchodzimy w interakcję przez dotyk.
Bibliografia i przypisy
Centers for Disease Control and Prevention [CDC]. (2022). Norovirus and rotavirus statistics. https://www.cdc.gov
Gerba, C. P., & Maxwell, S. (2012). Bacterial contamination of shopping carts and approaches to control. Food Protection Trends, 32(12), 747–749.
Gerba, C. P., et al. (2014). Bacterial contamination of computer touch screens. Journal of Hospital Infection, 86(3), 230–234.
SZÚ. (2025). Tisková zpráva: Infekce RSV je vysoce nakažlivá.
World Health Organization [WHO]. (2009). WHO guidelines on hand hygiene in health care.


Mariusz Duczek o trendach i nowościach w przyciskach oraz przełącznikach wandaloodpornych
Mariusz Duczek: Wpływ wojny w Ukrainie na globalną podaż litu
Maraton wykładów i warsztatów podczas dwudniowej konferencji B+R elektroniki Tomka Utkowskiego: O czym będą mówić prelegenci? 


![https://www.youtube.com/watch?v=gHcP8AajoN4 Szymon Robak oprowadza po katowickim Laboratorium Badań Kompatybilności Elektromagnetycznej w Sieć Badawcza Łukasiewicz - Instytucie Sztucznej Inteligencji i Cyberbezpieczeństwa. Zapraszamy na film! [materiał redakcyjny]](https://mikrokontroler.pl/wp-content/uploads/2026/06/Szymon-Robak-tytulowe.png)
![https://www.youtube.com/watch?v=BgxJVTwYJ-s Zapraszamy do obejrzenia filmu i wysłuchania krótkich wypowiedzi prelegentów Hardware Forum 2026 i organizatorów majowej konferencji dla inżynierów z branży elektronicznej: Konrad Bruliński z Lemontech, prof. Krzysztof Kulpa z Politechniki Warszawskiej, Zbigniew Huber z FLC, Ewa Załupska z firmy KROK, Jerzy Kozieł z MPTECH, Grzegorz Potyralski z VIGO Photonics, dr Krzysztof Czuba z Politechniki Warszawskiej, Anna Beata Kalisz Hedegaard z Quantum Security Defence, Adrian Cichosz z Elhurt Dystrybucja Anna Kamińska z Creotech Quantum, oraz Łukasz Jaeszke i Adam Jaeszke z TEK.day [materiał redakcyjny]](https://mikrokontroler.pl/wp-content/uploads/2026/05/tytulowe-film-1.png)

